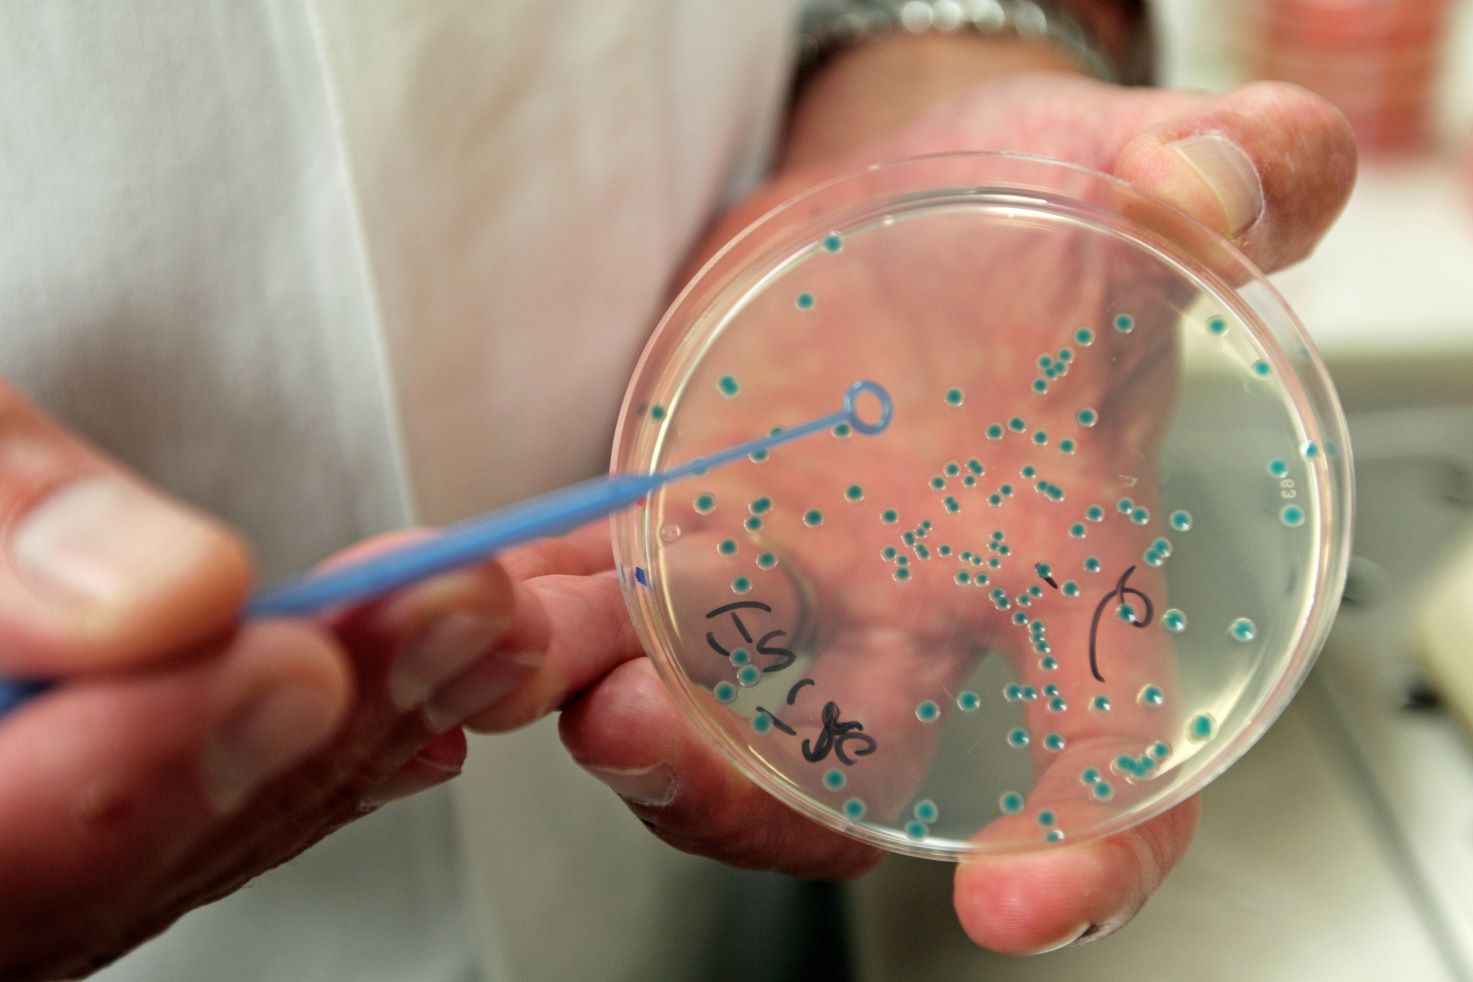

Die veränderte Sicherheitslage in Europa hat Gesundheitsschutz zu einem integralen Bestandteil der Neuausrichtung des Sanitätsdienstes auf Landes- und Bündnisverteidigung gemacht. Giftanschläge, Zerstörung von Infrastruktur, Sabotagen an Versorgungseinrichtungen, kontaminierte Lebensmittel und Desinformationskampagnen gefährden nicht nur die Logistik, sondern auch die Einsatzfähigkeit und das Vertrauen der Truppe. Real auftretende lebensmittel- oder trinkwasserbedingte Infektionen haben einen erheblichen Einfluss auf die militärische Operationsführung. Berichte über gezielte Kontamination von Nahrungsmitteln und Trinkwasser im UkraineKonflikt — von mit Arsen oder Rattengift versetzten Lebensmitteln bis zum Ausbruch bzw. zur Verbreitung von Tierseuchen — machen deutlich, wie niedrigschwellig und wirkungsvoll solche Bedrohungen sein können.
Um gesundheitliche Gefahren rechtzeitig zu erkennen und abzuwehren, arbeiten die Überwachungsstellen für ÖffentlichRechtliche Aufgaben und die Zentralen Institute des Sanitätsdienstes der Bundeswehr an der Schnittstelle von Kontrolle, Untersuchung und Beratung eng zusammen.
Ihre Aufgabe ist es, in kurzer Zeit belastbare Informationen zu liefern, schnell zu prüfen, ob Trinkwasser, Arzneimittel oder Verpflegungseinrichtungen sicher sind, eine natürliche Kontamination von einer gezielten Manipulation zu unterscheiden und auf dieser Basis operative Entscheidungen zu ermöglichen. Dafür verbinden sie veterinärmedizinische, pharmazeutische und lebensmittelchemische Analytik, feldtaugliche Laborinfrastruktur und standardisierte Qualitäts- und Rechtaufsichtsprozesse.
Überwachungsstellen für Öffentlich-Rechtliche Aufgaben des Sanitätsdienstes der Bundeswehr
Die Überwachungsstellen für Öffentlich-Rechtliche Aufgaben des Sanitätsdienstes der Bundeswehr (ÜbwStÖffRechtlAufgSanDstBw) nehmen die dem Sanitätsdienst im Bereich des Gesundheits- und Verbraucherschutzes zugewiesenen Aufgaben in ihrem jeweiligen regionalen Zuständigkeitsbereich als Ortsbehörde wahr.
Im Einzelnen werden hier Inspektions-, Beratungs- und Überwachungs- und Begutachtungsaufgaben in den Rechtsgebieten Infektionsschutz inklusive Trinkwasserhygiene, Medizinischer Arbeitsschutz, Arzneimittel- und Medizinprodukte, Verkehr mit Lebensmitteln und Bedarfsgegenständen, tierische Nebenprodukte, Tierschutz- und Tiergesundheit durchgeführt.
Weitere Aufgaben sind die Überprüfung von Diensthundeteams im Rahmen der Diensthundeprüfungsordnung der Bundeswehr sowie die Erstellung von Gutachten im Rahmen des Berufskrankheitenverfahrens. Für die Öffentlich-Rechtlichen Aufgaben betreiben die Überwachungsstellen ein Qualitätsmanagementsystem nach DIN ISO/IEC 17020.
Dies dient der Nachvollziehbarkeit, einheitlichen Dokumentation und flächendeckend gleichwertigen Aufgabenwahrnehmung gegenüber dem Rechtsunterworfenen (Truppe, Auftragnehmer, Verwaltung unter anderen).
Zentrale Institute des Sanitätsdienstes der Bundeswehr
Die Zentralen Institute des Sanitätsdienstes der Bundeswehr (ZInstSanBw) bilden das Pendant der Bundeswehr zu den zivilen Landesuntersuchungsämtern. Sie sind für veterinärmedizinische, pharmazeutische und lebensmittelchemische Untersuchungen für die Bundeswehr zuständig.
Ihre Fähigkeiten umfassen die Untersuchung und Begutachtung von Proben aus verschiedenen Bereichen. Dazu zählen Proben von Tieren, Lebensmitteln, Bedarfsgegenständen, Wasser, Arzneimitteln und Medizinprodukten sowie Umweltproben. Zudem haben die ZInstSanBw den öffentlich-rechtlichen Auftrag, amtliche Proben sowie Proben des Bundesmaßnahmenplans oder des Zoonosen- und des Tierseuchenmonitorings zu bearbeiten.
Die ZInstSanBw beteiligen sich im Rahmen von Sonderforschungsprogrammen an der wehrmedizinischen Forschung und entwickeln Analysemethoden und -verfahren. Dabei wird der Entwicklung feldtauglicher Methoden ein besonderes Augenmerk gewidmet. Die beiden ZInstSanBw betreiben und halten mobile containergestützte veterinärmedizinische, lebensmittelchemische und pharmazeutische Feldlabore vor.
Zudem bilden sie Sanitätsstabsoffiziere (SanStOffz) – Veterinäre und Apotheker – sowie das zugehörige, technische Personal in ihren jeweiligen fachlichen Schwerpunkten in Aufbau und Betrieb der Container aus: Veterinärmedizin in Kiel und Lebensmittelchemie bzw. Pharmazie in München. Die ZInstSanBw sind aufgrund rechtlicher Vorgaben nach DIN EN ISO/IEC 17025 für Prüf- und Kalibrierlaboratorien akkreditiert.
Sowohl die Überwachungsstellen als auch die ZInstSanBw bilden sachverständiges Personal (SanStOffz) und Assistenzpersonal in den Gesundheitsfachberufen aus und weiter. Zudem wird das Personal auf Einsatzverwendungen vorbereitet. Sie sind Truppensteller für Einsätze und Übungen, bei denen die Laborcontainer bzw. Zellen Force Health Protection (FHP) ausgebracht werden.
Die ZInstSanBw bilden zudem das Reach-Back für die Untersuchungen von Proben und die Beantwortung analytischer Fragestellungen für die Veterinärmedizin, Lebensmittelchemie und Pharmazie aus Einsätzen/Übungen und Szenarien, in denen keine Laborkapazitäten ausgebracht sind.
Die Überwachungsstellen übernehmen jeweils aus ihren fachlichen Schwerpunkten die Aufgaben im Sinne der FHP für Einsätze/Übungen und Szenarien, in denen keine Zelle FHP ausgeplant wurde, und bedienen temporären Dienstposten, d. h. stellen Sachverständige für zeitlich befristete Anwesenheiten im Übungs- bzw. Einsatzgebiet.
Direktorat Gesundheitsschutz und Gesundheitssicherheit
Mit Wirkung vom 01.04.2025 sind die Überwachungsstellen und die ZInstSanBw der Sanitätsakademie der Bundeswehr (SanAkBw) fachdienstlich und truppendienstlich unterstellt worden. Zudem wurde der SanAkBw die Aufgabe der Fachaufsicht über die Öffentlich-Rechtliche Aufgaben übertragen. Diese Aufgabe soll zukünftig in einem neuen Element Gesundheitsschutz und Gesundheitssicherheit wahrgenommen werden.
Dieses Aufgabengebiet umfasst:
- Das Führen der und die Fachaufsicht über die mit der Durchführung der öffentlich-rechtlichen Überwachung bzw. amtlichen Untersuchung beauftragten Stellen und Sachverständigen,
- die Gewährleistung einer einheitlichen Durchführung der Öffentlich-Rechtlichen Aufgaben durch fachliche Vorgaben,
- die Steuerung der rechtlich vorgeschriebenen Qualitätsmanagementsysteme der unterstellten Dienststellen,
- die Koordination von Vorgängen, die über die Zuständigkeit einer Ortsbehörde hinausgehen,
- die Bescheidung von Widersprüchen und Beschwerden gegen Bescheide und Anordnungen der Überwachungsstellen und
- die Bescheidung von Einsprüchen gegen Gutachten und Beanstandungen von Prüfberichten der ZInstSanBw sowie die Durchführung der gemäß A-840/12 zugewiesenen Genehmigungsverfahren.
Der Zuständigkeitsbereich der SanAkBw ist damit um einen erheblichen Anteil des Aufgabenkomplexes FHP erweitert worden und ermöglicht nun einen bruchfreieren und deutlich direkteren Wissens- und Kenntnistransfer zwischen ÖRA/FHP, Medical Intelligence und Information (MI2) sowie FHP-Nexus, Forschung und Ausbildung.
Die sich aus der veränderten Sicherheitslage ergebenden Herausforderungen und Bedrohungen erfordern aufgrund des zu erwartenden Aufgabenzuwachses und der veränderten Aufgabenqualität eine strukturelle und inhaltliche Anpassung auch im Bereich der Überwachungsstellen und Zentralen Institute.
Blick in die Zukunft – Zentren für Gesundheitsschutz
Es ist beabsichtigt, die vier Überwachungsstellen und zwei ZInstSanBw mit ihren Außenstellen unter Beibehaltung der regionalen Ortsbehördenfunktion sowie der Präsenz in der Fläche zu Zentren für Gesundheitsschutz umzubauen. Dadurch sollen das gestiegene Aufgabenaufkommen und die veränderten Aufgaben kompensiert werden. Dennoch wird es bei einem gleichbleibenden Personalansatz notwendig sein, Aufgaben, die nicht zwingend militärisch abzubilden sind, an externe Dienstleister zu vergeben.
In der vermutlich dauerhaft verschärften Sicherheitslage – verursacht durch einen staatlichen Akteur – hat sich die Qualität der Bedrohungen durch Anschlagsszenarien und Sabotageakte im Vergleich zu den vorangegangenen terroristisch motivierten Szenarien deutlich verändert. Die Tatsache, dass Gifte und Mikroorganismen, einschließlich Viren, die für Anschläge auf die Lebensmittelkette, die Landwirtschaft, die Trinkwasserversorgung oder die Bevölkerung einschließlich des Truppenkörpers eingesetzt werden können, so vielfältig sind, führt nun dazu, dass Maßnahmen ergriffen werden müssen, die den Fokus von Sabotageschutzmaßnahmen nicht nur auf die Einsatzgebiete richten dürfen.
Daher ist unter anderem dem Aufgabenfeld „Food und Water Defence“ in Zukunft deutlich mehr Aufmerksamkeit zu widmen. Um im Ernstfall schnell reagieren zu können, ist es unerlässlich, neben dem Sabotageschutz bei Verpflegungseinrichtungen und den Wasserversorgungsanlagen, im Einkaufsprozess Food-Defence-Maßnahmen zu berücksichtigen. Dies beinhaltet auch die Auditierung von Lieferbetrieben und der Transportabsicherung. Zudem sind effektive analytische Schnellmethoden erforderlich, um z. B. im Anschlagsfall verdächtige Lebensmittel auszuschließen bzw. die Nutzbarkeit von Trinkwasserversorgungsanlagen beurteilen zu können.
Die erhöhte Übungstätigkeit der Truppe sowie die Notwendigkeit schneller Verlegefähigkeit ergeben weitere Herausforderungen, denen u. a. mit den Convoy Support Centern begegnet wird. Diese Center werden ebenfalls einen zusätzlichen Aufsichts- und Beratungsbedarf in allen angesprochenen Rechtsgebieten mit sich bringen. Dies umfasst neben der Feld- und Trinkwasserhygiene, der Lebensmittelsicherheit, dem Tierschutz bei Einheiten, die mit Diensttieren verlegen, auch den Bereich des medizinischen Arbeitsschutzes, z. B. bei den Verladungs-, Tank- und Rastvorgängen.
Nicht unerwähnt bleiben darf der Schutz Deutschlands und benachbarter Nationen vor der Verschleppung von Tierkrankheiten und biologischen Risiken. Daher wird auch der Beratungsbedarf zu tierseuchenprophylaktischen Maßnahmen sowie deren Kontrolle und die Bescheinigung der Freiheit von Tierseuchenerregern durch veterinärmedizinische Sachverständige ein Faktor sein, der für die Verlegung der Truppe eine erhebliche Bedeutung haben wird. Um Verzögerungen zu vermeiden, ist ein ausreichender Personalansatz zur Bewältigung der zu erwartenden Überprüfungs- und Beratungsumfänge bei gleichbleibendem Personalkörper nur unter Hintanstellung anderer Aufgaben zu gewährleisten.
In den geplanten Zentren für Gesundheitsschutz der Bundeswehr werden die Fähigkeiten im Bereich Gesundheits- und Verbraucherschutz innerhalb der Bundeswehr sowie die Anknüpfungs- und Kooperationsstellen zu den zahlreichen regionalen zivilen Institutionen als zivile Anteile der Gesamtverteidigung abgebildet werden.
Neben der fachlichen Kompetenz ist allerdings auch ein möglicherweise zentral auszubringendes, aufwuchs- und durchhaltefähiges Lage- und Führungszentrum zu schaffen. Bereits im Grundbetrieb (z. B. Übungen), bei Sonderlagen (z. B. SARS-CoV-2 Pandemie, Tierseuchenausbrüche) und insbesondere im Falle der Aktivierung des Reinforcement and Sustainment Networks oder bei Landes- und Bündnisverteidigung kommt es zu einem deutlich steigenden Aufwand im Bereich der militärischen und militärisch-zivilen Koordination, der die Führungsgrundgebiete und alle Fachgebiete der Zentren für Gesundheitsschutz direkt und ggf. zeitgleich fordert.
Zusammengefasst dienen die Überwachungsstellen und die ZInstSanBw keinem akademischen Selbstzweck – sie sind aktiver Gesundheitsschutz für die Truppe. Unabhängig von der Ausgestaltung der Zentren Gesundheitsschutz bleibt der Anspruch bestehen: Effektiv handeln, präzise analysieren und gezielt schützen – für sichere Lebensmittel, sauberes Trinkwasser und die Gesundheit unserer Soldatinnen und Soldaten.
Aus Wehrmedizin und Wehrpharmazie 4/2025
Für die Verfasser:
Oberstveterinär Dr. Michael Nippgen
ÜbwStÖffRechtlAufgSanDstBw Ost
Kaiser-Friedrich Str. 69–61
14469 Potsdam
Mit WhatsApp immer auf dem neuesten Stand bleiben!